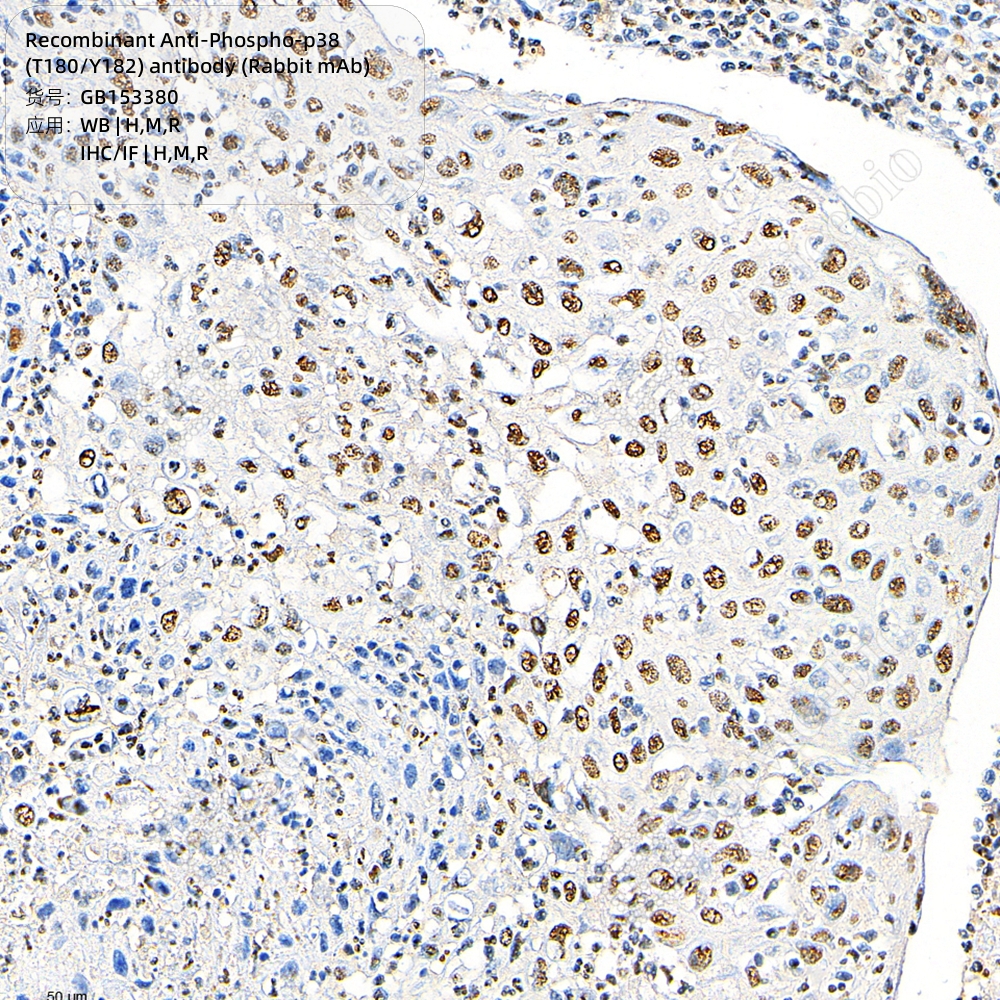
现货 Recombinant Anti-Phospho-p38 (T180/Y182) antibody (Rabbit mAb) GB153380 100ul 科研生物实验抗体 - 图1
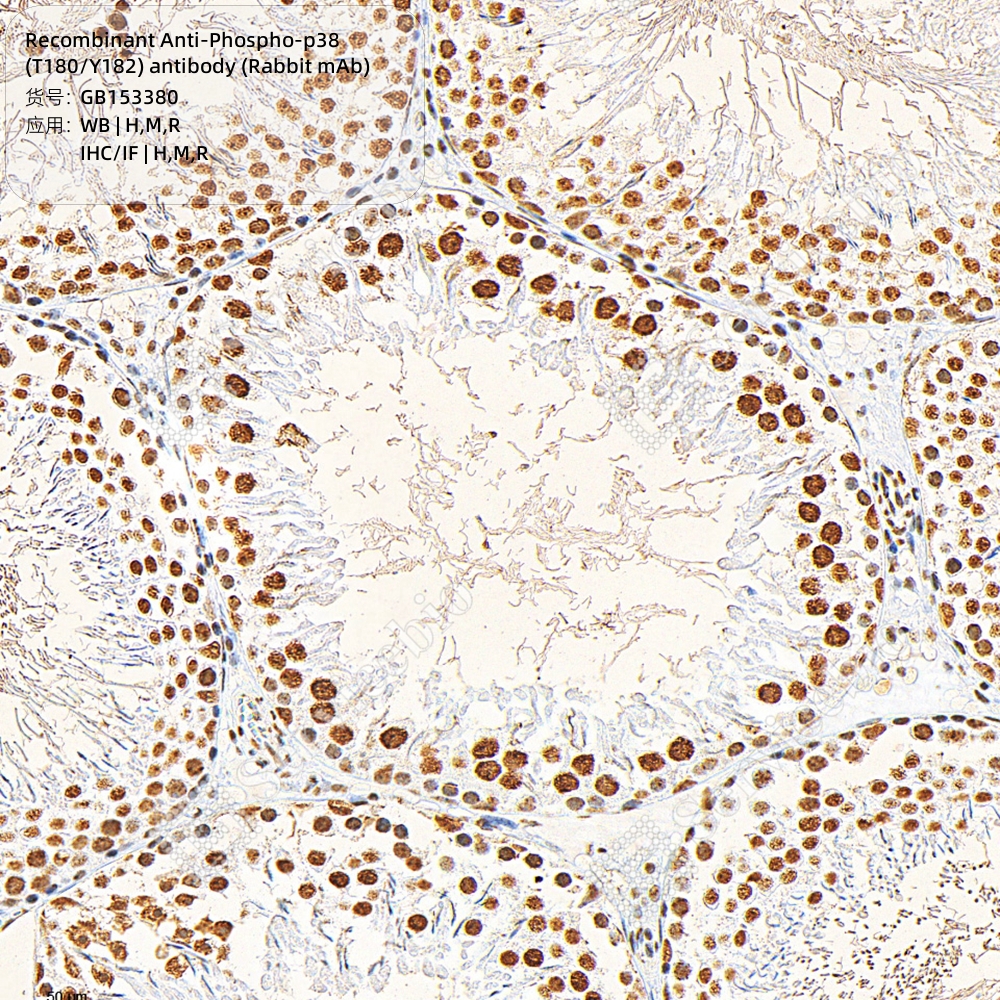
现货 Recombinant Anti-Phospho-p38 (T180/Y182) antibody (Rabbit mAb) GB153380 100ul 科研生物实验抗体 - 图2

现货 Recombinant Anti-Phospho-p38 (T180/Y182) antibody (Rabbit mAb) GB153380 100ul 科研生物实验抗体
店铺:Servicebio思克宝专卖店 品牌:SERVICEBIO 地址:湖南 长沙 商城:天猫

店铺:Servicebio思克宝专卖店 品牌:SERVICEBIO 地址:湖南 长沙 商城:天猫
 文具电教/文化用品/商务用品
1187.5
满件折
文具电教/文化用品/商务用品
1187.5
满件折
天猫好物 SERVICEBIO
优惠296.87元 专利小光具座 新升级水透镜 潜望镜
56
低价
专利小光具座 新升级水透镜 潜望镜
56
低价
销量95 学友(科学仪器)
购买 文具电教/文化用品/商务用品
10
低价
文具电教/文化用品/商务用品
10
低价
销量4 文具电教/文化用品/商务用品
购买 文具电教/文化用品/商务用品
69
折扣
文具电教/文化用品/商务用品
69
折扣
销量61 成日新光
购买 教材同步 全国各版本通用 备战中考
59
折扣
教材同步 全国各版本通用 备战中考
59
折扣
天猫好物 知启
购买 电泳电极头/转印电极头 通用伯乐/天能
24.5
券后价
电泳电极头/转印电极头 通用伯乐/天能
24.5
券后价
销量15 锡萌
1元优惠券 文具电教/文化用品/商务用品
13.2
低价
文具电教/文化用品/商务用品
13.2
低价
销量87 APK
购买 无酶 无热源 荧光定量PCR板
61.5
低价
无酶 无热源 荧光定量PCR板
61.5
低价
销量73 文具电教/文化用品/商务用品
购买 文具电教/文化用品/商务用品
32
折扣
文具电教/文化用品/商务用品
32
折扣
销量82 胜凡(办公用品)
购买 磁性几何演示器四年级上册数学教具几何图形
5.22
满件折
磁性几何演示器四年级上册数学教具几何图形
5.22
满件折
天猫好物 满袋阳光
优惠0.58元